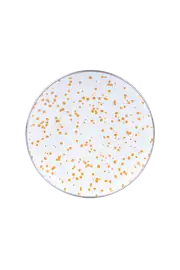
EMAYlab

Black Cupid Emaye Kettle
Metal Paslanmaz Çelik Tetikli Un Eleği, Pratik Un ve Şeker Eleği
Paslanmaz Çelik Kızartma Kevgiri – Metal Saplı Patates, Kabak ve Sebze Süzgeci
Ayarlanabilir Paslanmaz Çelik Metal Boncuk Top Uçlu Sos Karıştırıcı ve Yumurta Çırpıcı
Emaylab Profesyonel Paslanmaz Çelik Patates Ezici – Dayanıklı Püre Yapıcı Aparat
Isıya Dayanıklı Silikon Spatula – Geniş Yanmaz Yapışmaz Börek ve Pasta Spatulası
Ahşap Bambu Mini Ölçek Baharat Kaşığı 12'li Set – 7 cm
Paslanmaz Çelik Hazneli Sarımsak Ezici – Ergonomik Tutma, Soymadan Ezme, Çıkarılabilir Hazneli
EmaylabXYirmiyediKuzguncuk Christmas Carousel Emaye Kupa Pastel Yeşil
EmaylabXYirmiyediKuzguncuk Christmas Carousel Emaye Kupa
Black Cupid Şekerlik
Emaye Merry 4’lü kase Çerezlik, Kahvaltılık, Reçellik, Zeytinlik, Sunumluk Seti 8cm 200 ml
EMAYlab Merry Pasta/sunum Tabağı 21cm
Emaylab Silikon 3’lü Set Yemek Servis Kaşığı Asılabilir Kaşık, Yanmayan Silikon Kaşık
Mood Emaye Çaydanlık Takımı Ahşap Tepeli
Star Emaye 4’lü kase Çerezlik, Kahvaltılık, Reçellik, Zeytinlik, Sunumluk Seti 8cm 200 ml
Black Cupid Emaye 4’lü kase Çerezlik, Kahvaltılık, Reçellik, Zeytinlik, Sunumluk Seti 8cm 200 ml
Speckles Emaye 4’lü kase Çerezlik, Kahvaltılık, Reçellik, Zeytinlik, Sunumluk Seti 8cm 200 ml - Cobalt
Speckles Emaye 4’lü kase Çerezlik, Kahvaltılık, Reçellik, Zeytinlik, Sunumluk Seti 8cm 200 ml - Pembe
Speckles Emaye 4’lü kase Çerezlik, Kahvaltılık, Reçellik, Zeytinlik, Sunumluk Seti 8cm 200 ml - Bebe mavisi
Masa düzeni, yemek deneyiminin en önemli parçasıdır ve doğru sunum, lezzetin algısını artırır. Emaye ürünler, estetik ve fonksiyonelliği bir arada sunan ideal malzemelerdir. Hem rustik hem de modern çizgiler taşıyan bu ürünler, sofrada dayanıklılığı ve şıklığı temsil eder. Doğru kombinasyonlar, yemeklerin görsel cazibesini yükseltir. Bu nedenle, emaye servis tabağı, emaye sosluk ve emaye sunum tepsisi gibi ürünlerin kullanımı özenle planlanmalıdır.
Hangi Tabakta Ne Servis Edilir?
İyi bir sunumun temel taşlarından biri, doğru tabak seçimi ve kullanım amacına uygun yerleştirmedir. Öncelikle, çorba tabağı, sıvı yemeklerin sunumu için vazgeçilmezdir. Emayenin ısı tutma özelliği, çorbanın sıcaklığını korumasına yardımcı olur. Aynı zamanda, bu tabaklar, hafif yapıları sayesinde taşıma kolaylığı sağlar ve sofraya nostaljik bir hava katar. Ana yemeklerin servisinde ise servis tabağı kullanımı önceliklidir. Bu tabaklar, geniş yüzeyleriyle et, sebze veya pilav gibi yemeklerin şık bir düzen içinde sunulmasına olanak tanır.
Öte yandan, sunum tabakları küçük porsiyonlar veya aperatifler için idealdir. Çeşitli boyut ve tasarımlarda bulunabilen bu tabaklar, mezelerin, peynirlerin veya tatlıların sunumunu estetikleştirir. Emaye sunum tabakları, klasik tasarımları ve canlı renk seçenekleriyle sofraya zenginlik katar. Son olarak, sosların ve diplerin servisinde emaye sosluk tercih edilmelidir. Küçük boyutları ve kullanışlı yapılarıyla, sofrada düzen ve kolay erişim sağlar. Emayenin temizlenme kolaylığı, bu ürünleri tercih sebebi haline getirir.
Tabak Yerleşimi Nasıl Yapılır?
Masa sunumunda tabak yerleşimi, işlevsellik ve görselliğin dengelenmesiyle başarılı olur. İlk olarak, servis tabağı her misafirin önüne doğru hizada yerleştirilmelidir. Bu tabak, ana yemeğin sunulduğu temel parçadır ve servis kolaylığı için masaya paralel konulmalıdır. Tabak ile masa kenarı arasında en az 2-3 cm boşluk bırakmak, rahat kullanım sağlar.
Çorba tabağı, servis tabağının üstüne yerleştirilebilir veya servis tabağının sol üst köşesine konumlandırılır. Bu yerleşim, çorba servisi sırasında misafirin rahatça erişebilmesi ve yemeğin sıralı akışının korunması açısından önemlidir.
Ara sıcaklar veya küçük porsiyonlar için kullanılan sunum tabakları, masada daha esnek yerlerde konumlandırılır. Genellikle servis tabağının yanında veya masanın ortasında paylaşım için uygun alanlarda yer alırlar. Bu tabakların yerleşimi, yemeğin türüne göre değişebilir; örneğin, meze tabakları masanın ortasına yerleştirilirken, tatlı tabakları servis sonrası için kenarda bekletilebilir.
Sosların ve küçük garnitürlerin servisinde kullanılan emaye sosluk ana tabaklara yakın ama masa düzenini bozmayan şekilde konumlandırılır. Sosluklar, küçük bir emaye sunum tepsisi üzerinde düzenlenerek servis kolaylığı ve masa düzeninin korunması sağlanabilir.
Çatal, bıçak ve kaşık gibi servis araçlarının tabaklara göre konumlandırılması da önemlidir. Çatal sol tarafta, bıçak ve kaşık sağ tarafta yer almalı, kullanışlı ve ergonomik bir düzen kurulmalıdır.
Sunum Tabağı Tercihi Nasıl Olmalı?
Sunum tabağı seçimi, masa düzeninin ve yemek sunumunun kalitesini doğrudan etkiler. Öncelikle, tabağın malzemesi ve dayanıklılığı göz önünde bulundurulmalıdır. Emaye sunum tabakları, çizilmeye ve ısıya dayanıklı yapılarıyla uzun ömürlü kullanım sağlar. Ayrıca, hafif olmaları taşıma ve servis kolaylığı yaratır. Bu özellikler, profesyonel ve ev kullanımı için önemli avantajlar sunar. Boyut, sunum tabağı tercihinde ikinci önemli faktördür. Tabağın büyüklüğü, sunulacak yiyeceğin hacmine göre belirlenmelidir. Çok küçük tabaklar, yemekleri sıkıştırır ve görsel olarak zayıf bir sunuma neden olurken, aşırı büyük tabaklar ise boşluk hissi yaratır.
Renk seçimi, sunum tabağının estetik başarısını artırır. Emaye sunum tabakları canlı ve pastel tonlarda üretilebilir. Beyaz veya açık renkler yiyeceğin doğal renklerini ön plana çıkarırken, koyu renkler sofistike bir kontrast oluşturur. Tabak rengi ile masa örtüsü ve diğer sunum araçları arasındaki uyum, bütünlük sağlar. Fonksiyonellik de göz ardı edilmemelidir. Sunum tabaklarının kenar yapısı, taşıma ve servis sırasında kolaylık sunmalıdır. Ayrıca, tabakların bulaşık makinesinde yıkanabilir olması ve kolay temizlenmesi pratikliği artırır.
Masa sunumunda doğru ürünleri seçmek, yemeğin lezzetini ve deneyimini artırır. Emaye servis tabağı, sunum tabakları, emaye sosluk ve emaye sunum tepsisi gibi kaliteli ürünler, sofranıza şıklık ve fonksiyonellik katar. Her detayın özenle planlandığı sunumlar, misafirlerinizde kalıcı bir izlenim bırakır. Sofranızı emaye ürünlerle donatmak için güvenilir adres Emaylab’ı ziyaret etmeyi unutmayın.